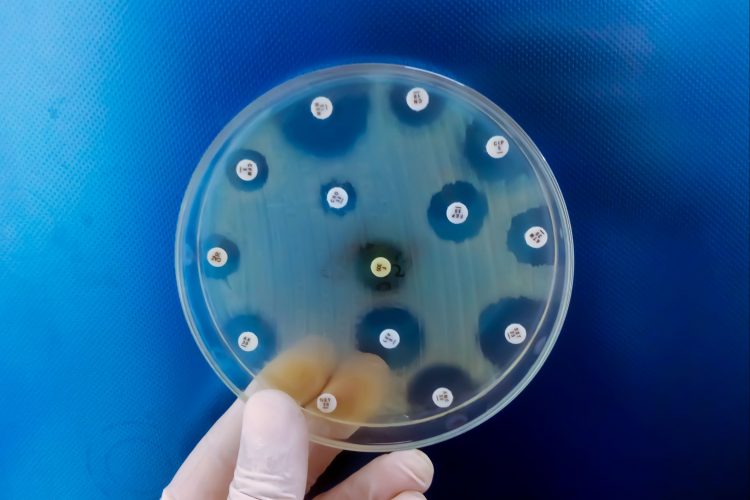
Τα αρχαιότερα μικρόβια ίσως κρατούν το κλειδί κατά της αντοχής στα αντιβιοτικά

Μονοκύτταροι οργανισμοί που επιβιώνουν εδώ και δισεκατομμύρια χρόνια, γνωστοί ως Αρχαία (Archaea), περιέχουν ουσίες με ισχυρή αντιβιοτική δράση, που θα μπορούσαν να αποτελέσουν τη βάση για νέα φάρμακα κατά της ανθεκτικότητας στα αντιβιοτικά, σύμφωνα με μελέτη του Πανεπιστήμιου της Πενσυλβάνια στις ΗΠΑ.
Τα μικρόβια, και ειδικότερα τα Αρχαία, διαφέρουν σημαντικά από τα βακτήρια, τα φυτά, τα ζώα και τους μύκητες. Αν και μοιάζουν με βακτήρια, τα Αρχαία ξεχωρίζουν ως προς τη βιοχημεία, τις κυτταρικές μεμβράνες και τα γενετικά τους χαρακτηριστικά. Επιβιώνουν σε ακραίες συνθήκες, όπως θερμές πηγές, υποθαλάσσια ηφαιστειακά ανοίγματα και περιοχές με υψηλή τοξικότητα- γεγονός που ενδεχομένως τα ανάγκασε να αναπτύξουν μοναδικούς αμυντικούς μηχανισμούς.
«Εστιάσαμε στα Αρχαία επειδή αναγκάστηκαν να αναπτύξουν βιοχημικές άμυνες σε ασυνήθιστα περιβάλλοντα», εξηγεί ο Μαρτσέλο Τόρρες, ερευνητής στο εργαστήριο του επικεφαλής της μελέτης Σεζάρ ντε λα Φουέντε και συν-συγγραφέας της μελέτης.
Ο επικεφαλής ερευνητής Σεζάρ ντε λα Φουέντε τονίζει ότι η μελέτη αυτή αποτελεί μόνο την αρχή.
«Τα Αρχαία είναι από τις αρχαιότερες μορφές ζωής στον πλανήτη- και έχουν πολλά να μας διδάξουν για το πώς να αντιμετωπίσουμε τα σημερινά παθογόνα» λέει χαρακτηριστικά.
Ο ρόλος της τεχνητής νοημοσύνης
Στο παρελθόν, το εργαστήριο του Σεζάρ ντε λε Φουέντε έχει αξιοποιήσει μοντέλα τεχνητής νοημοσύνης για να εντοπίσει πιθανά αντιβιοτικά σε ποικίλες πηγές – από το DNA εξαφανισμένων οργανισμών έως τα χημικά συστατικά δηλητηρίων ζώων. Για αυτή τη μελέτη, οι ερευνητές χρησιμοποίησαν ένα εργαλείο τεχνητής νοημοσύνης με την ονομασία APEX – που αναπτύχθηκε στο ίδιο εργαστήριο – προκειμένου να εντοπίσουν υποψήφιες αντιβιοτικές ενώσεις σε αυτούς τους μικροοργανισμούς. Το APEX είχε προηγουμένως αναλύσει χιλιάδες πεπτίδια (βραχείες αλυσίδες αμινοξέων) με γνωστές αντιμικροβιακές ιδιότητες και έτσι μπορεί να προβλέψει αν μια νέα ακολουθία αμινοξέων θα έχει παρόμοια δράση.
Με την αναβάθμιση του APEX 1.1 και την ενσωμάτωση επιπλέον δεδομένων από πεπτίδια και παθογόνα βακτήρια, οι ερευνητές βελτίωσαν την ικανότητα του εργαλείου να εντοπίζει ποια μόρια αυτών των μικροοργανισμών μπορούν να αναστείλουν την ανάπτυξη βακτηρίων.
Συνολικά, σε ανάλυση 233 ειδών Αρχαίων, το APEX εντόπισε πάνω από 12.000 πιθανά αντιβιοτικά μόρια, τα οποία οι επιστήμονες ονόμασαν “ archaeasins”. Η χημική ανάλυση έδειξε πως αυτά διαφέρουν από τα γνωστά αντιμικροβιακά πεπτίδια, κυρίως ως προς την κατανομή των ηλεκτρικών φορτίων τους.
Στη συνέχεια, οι ερευνητές επέλεξαν 90 μόρια για δοκιμή έναντι φυσικών βακτηρίων.
«Η αναζήτηση νέων αντιβιοτικών μόριο προς μόριο είναι σαν να ψάχνεις βελόνα στα άχυρα», σημειώνει ο Φάνγκπιν Γουάν, συν-συγγραφέας. «Η τεχνητή νοημοσύνη επιταχύνει τη διαδικασία, δείχνοντάς μας πού είναι πιθανότερο να βρίσκονται οι βελόνες» προσθέτει.
Πώς καταπολεμούν τα μόρια αυτά τα ανθεκτικά βακτήρια
Τα συγκεκριμένα μόρια επιτίθενται στο εσωτερικό των βακτηρίων, διαταράσσοντας τα ηλεκτρικά σήματα που διατηρούν ζωντανό το κύτταρο – αντίθετα από τα συνήθη αντιμικροβιακά πεπτίδια που προσβάλλουν το εξωτερικό περίβλημα. Στις αρχικές δοκιμές, 80 μόρια εξετάστηκαν σε ένα παθογόνο βακτήριο με αντοχή στα φάρμακα: το 93% έδειξε αντιμικροβιακή δράση έναντι τουλάχιστον ενός βακτηρίου, και τρία από αυτά επιλέχθηκαν για περαιτέρω μελέτη σε ζωικά μοντέλα.
Τέσσερις ημέρες αργότερα διαπιστώθηκε πως όλα τα μόρια ανέστειλαν την ανάπτυξη του ανθεκτικού βακτηρίου – του τύπου που εντοπίζεται συχνά σε ενδονοσοκομειακές λοιμώξεις. Το ένα από αυτά είχε παρόμοια αποτελέσματα με την πολυμυξίνη Β, ένα ισχυρό «έσχατο» αντιβιοτικό που χρησιμοποιείται όταν όλα τα άλλα αποτυγχάνουν.
Η ομάδα σκοπεύει να βελτιώσει περαιτέρω το APEX ώστε να προβλέπει την αντιβιοτική δράση με βάση τη δομή των μορίων. Παράλληλα, σχεδιάζει να μελετήσει τη μακροπρόθεσμη επίδραση των εν λόγω μορίων, με τελικό στόχο την έναρξη κλινικών δοκιμών σε ανθρώπους.
Η μελέτη δημοσιεύθηκε στο περιοδικό Nature Microbiology.
Πηγές: www.ertnews.gr